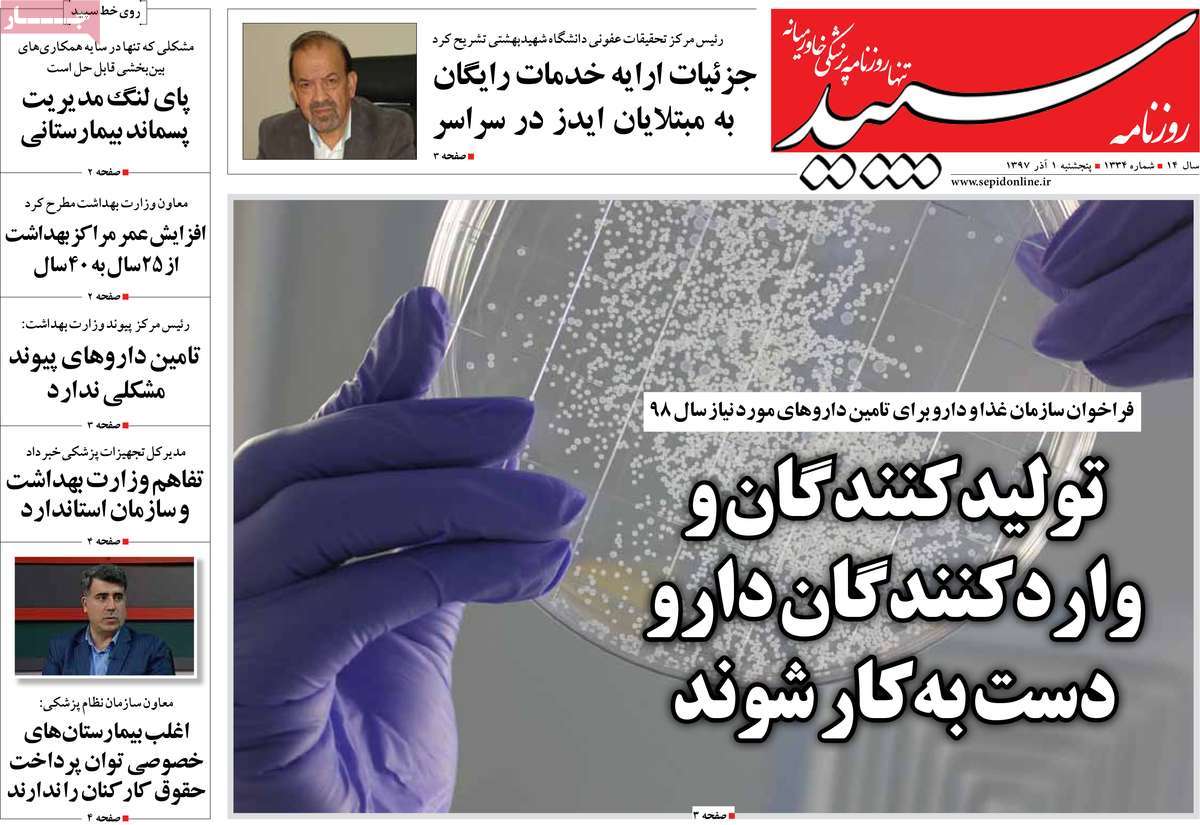

رسانه
صفحه اول روزنامه های کشوری و استانی؛ پنج شنبه یکم آذرماه 1397 /تصاویر

در این بخش هر روز جلد اغلب روزنامه هایی که در سراسر کشور منتشر می شوند را مشاهده می کنید.
سعی کرده ایم صفحه اول بسیاری از روزنامه های استانی را نیز منتشر کنیم تا به نوعی از اخبار آنها نیز مطلع شویم.